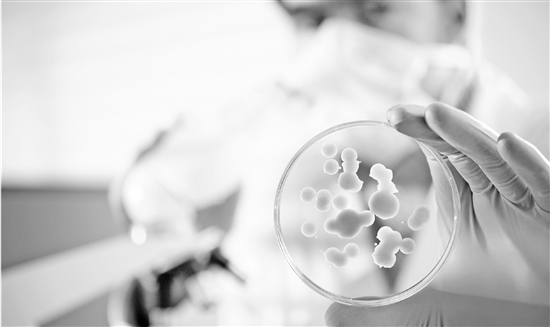

-
5G时代 你的手机升级了吗?
市民何小姐近来频频接到运营商客服推广5G套餐的电话,“资费套餐要过百元,暂时就不考虑升5G了”。记者走访市场了解到,对于正式“落地”一周年的5G商用,市场端“铺天盖地”的推广。
2020-10-28 10:20:02 -
疟疾如何在旱季蛰伏?最新研究称恶性疟原虫改变基因表达
恶性疟原虫是导致疟疾的主要寄生虫,通过改变自己的基因表达,这种疟原虫能在旱季少量存留于人类血液中,但又不会导致疾病。
2020-10-27 18:26:15 -
智慧助老帮老年人迈“数字鸿沟”
帮助老年人迈过“数字鸿沟”,需要社会通力合作。为此,北京市老龄办、北京市老龄协会今天发布了“数字时代,与您同行——智慧助老行动倡议书”。
2020-10-26 07:22:47 -
专家热议智慧养老:前景广阔但更需人文温度
智慧远程看护系统、感知摄食行为可穿戴设备、老年人智能餐具……智慧养老产品和应用日新月异,不断突破想象。专家和业内人士认为,智慧养老前景广阔,未来发展应注重以人为本。
2020-10-25 19:22:11 -
嫦娥四号完成第23月昼工作
嫦娥四号着陆器和“玉兔二号”月球车完成第23月昼工作,分别于10月23日21时40分和12时,按地面指令完成月夜模式设置,进入月夜休眠。截至今天,嫦娥四号着陆器和“玉兔二号”月球车已在月球背面顺利工作660个地球日,累计行驶565.9米。
2020-10-24 15:57:15 -
椰毒假单胞菌 不易察觉的“凶嫌”
经过研究确认,“酸汤子”是被一种叫做“椰毒假单胞菌”的微生物污染的。夺走那9人生命的,正是这种细菌产生的致命毒素。
2020-10-24 14:47:07 -
这种“懒惰”的细胞 也能闻到“气味”
我们的神经组织除了神经元,还有一类重要的细胞——神经胶质细胞。神经胶质细胞与神经元如同一对孪生兄弟相伴而生,胶质细胞通常对神经元起着支持、保护、营养等作用,悉心呵护着它。
2020-10-24 14:43:57 -
科学家发现人体新器官咽鼓管唾液腺
据美国趣味科学网站20日报道,荷兰科学家意外在人体喉咙上部深处发现了一组秘密的唾液腺。他们表示,这个新器官对于癌症治疗中减少副作用具有重要意义。
2020-10-24 11:29:21 -
我国再创亚洲陆上最深定向井纪录
记者昨天(23日)从中国石化了解到,位于新疆塔里木盆地的顺北53-2H井完钻井深达8874.4米,再创亚洲陆上最深定向井纪录。
2020-10-24 10:57:23 -
三江源冰川科考在青海启动
近日,由中科院青藏高原研究所牵头,中科院西北生态环境资源研究院、中科院沈阳自动化研究所、西北大学、中国极地研究中心、华东师范大学等单位参与的三江源冰川科学考察在黄河源区启动。
2020-10-24 08:25:54 -
当“好奇青年”遇上“硬核科技”
近日,2020世界青年科学家峰会系列活动在浙江温州举行,“硬核科技”与“好奇青年”碰撞出金石铿锵,也点亮了年轻学子的科学梦想。
2020-10-23 09:54:08

×